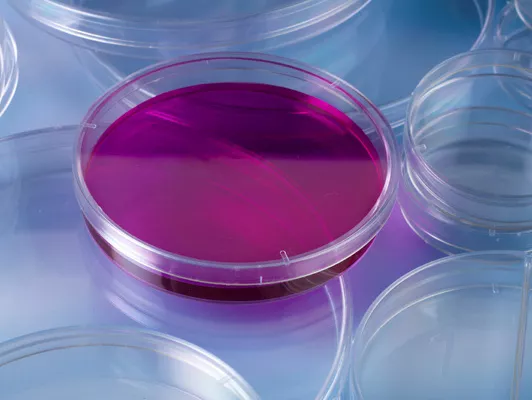

ООО «Пластилаб Индустрия» — компания, которая занималась производством изделий из пластмасс.
Она была зарегистрирована 18 марта 2016 года в городском посёлке Фёдоровское (Тосненский район, Ленинградская область) по адресу: Малая улица, дом 6Г.
Основной профиль деятельности компании «ПЛАСТИЛАБ» - снабжение лечебно-профилактических учреждений России и стран СНГ лабораторными расходными материалами, лабораторным оборудованием, хирургическим инструментом и многим другим медицинским оборудованием ведущих зарубежных и Российских производителей.
Продукция компании соответствует международным стандартам качества и стандартам РФ. Вся продукция завода имеет Российские сертификаты качества и регистрационные удостоверения!
Удовлетворенность клиента – приоритет для PLASTI LAB!
Наша цель – постоянно развиваться и совершенствоваться, гарантируя полную удовлетворенность клиента!